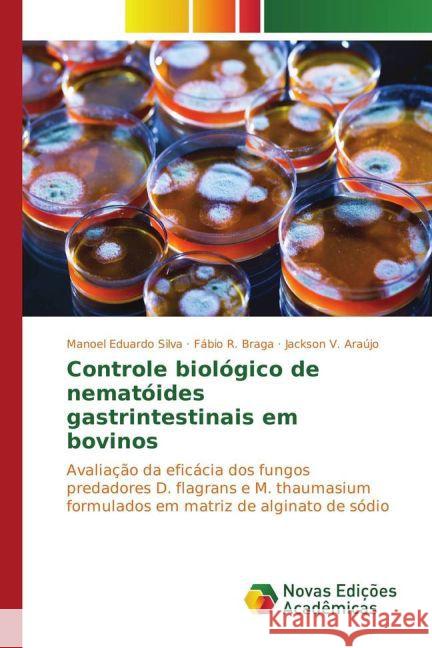
Controle biológico de nematóides gastrintestinais em bovinos : Avaliação da eficácia dos fungos predadores D. flagrans e M. thaumasium formulados em matriz de alginato de sódio

topmenu
Jackson, R. V.
About the Author J.A.JACKSON is an author who lives in an enchanted little house she calls home in the Northern California foothills with her husband and Big Sally an American scent hound. She fell in love with writing as a small child. She was born in Arkansas and comes from a family rich in story tellers. She spent over ten years working in the non-profit sector where she wrote grants, press releases and contributed many stories to their newsletter. She was their Newsletter editor for over ten years. She loves growing roses, a good pot of hot tea, chocolate, magical stories, suspense stories...